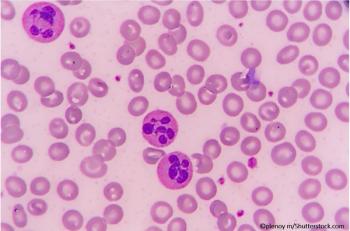

Patient complains of pain and severe vision loss; initial impression, hyphema. Proceed with standard treatment, or not?

Patient complains of pain and severe vision loss; initial impression, hyphema. Proceed with standard treatment, or not?

Fifty-year-old female w/ HTN, DM seen in ED for palpitations, near-syncope. Weak rapid pulse (210 bpm), BP 75/35 mmHg. What's your ECG read?


Myosis is accompanied by acute onset dizziness, double vision, and asthenia. What's in your differential diagnosis?

What does the office-based ECG tell you about the patient's complaint of recently worsening asthenia and dyspnea?

Hallucinations and rambling speech came on suddenly and are getting worse. Review history and ECG. What's your diagnosis?
A 75-yo man presents with worsening asthenia and exertional dyspnea x2 weeks. Based on labs and CXR, what is your next step?

What type of injury is seen on this x-ray of a young boy's elbow? Outward signs of trauma are negligible.

A rare condition, HUS is a form of microangiopathic hemolytic anemia, the #1 cause of renal failure in children.

What cause of hypouresis after several days of emesis/diarrhea has resolved? Look for clues in the lab results.

The patient with hypertension and syncope had cardiac tamponade. Causes, symptoms, and treatment described here.

A man with a history of hypertension had syncope and felt “sweaty.” Chest x-ray was normal. What’s your next test?


Patient describes 2 short "spells," one of blurry vision and another of tingling in an extremity. Tinnitus begins in your office.


Epigastric pain x3 days in an otherwise healthy middle-aged man prompts an in-office abdominal ultrasound. What do you see?

What is the plant most likely responsible for these symptoms and how would you treat?

A middle-aged man who has not seen a doctor in "years" presents with nausea, vomiting, and asthenia that have worsened over "weeks to months." Your EKG read?

What is the cause of this severe rash in a 60-year-old man with HIV?


Does the abdominal CT shown offer a clue to the cause of this repeat but markedly more severe episode of hematochezia?

The pruritic rash covers much of the 23-year-old's body. Other than a recent UTI, PMH is negative. Do labs help with your Dx?

A 32-year-old man visits the ED for an oral canker sore that should have run its course but is getting worse. What one question should you ask?

What do the symptoms and ultrasound image associated with the patient's pain suggest? Would you discharge her to home?


A 32-year-old man arrives at the ED unable to walk after jumping from a wall. This foot injury is often missed on x-ray. Do you see it?

Missed fractures of the foot are not uncommon. Examine the lateral x-ray view of this injury carefully to understand why.

What might be the cause of purple urine in the Foley bag attached to an indwelling catheter in an elderly bedridden woman?


She comes to your ED with a wide range of symptoms but results of her physical examination are WNL. Given her presentation, what's in your workup?